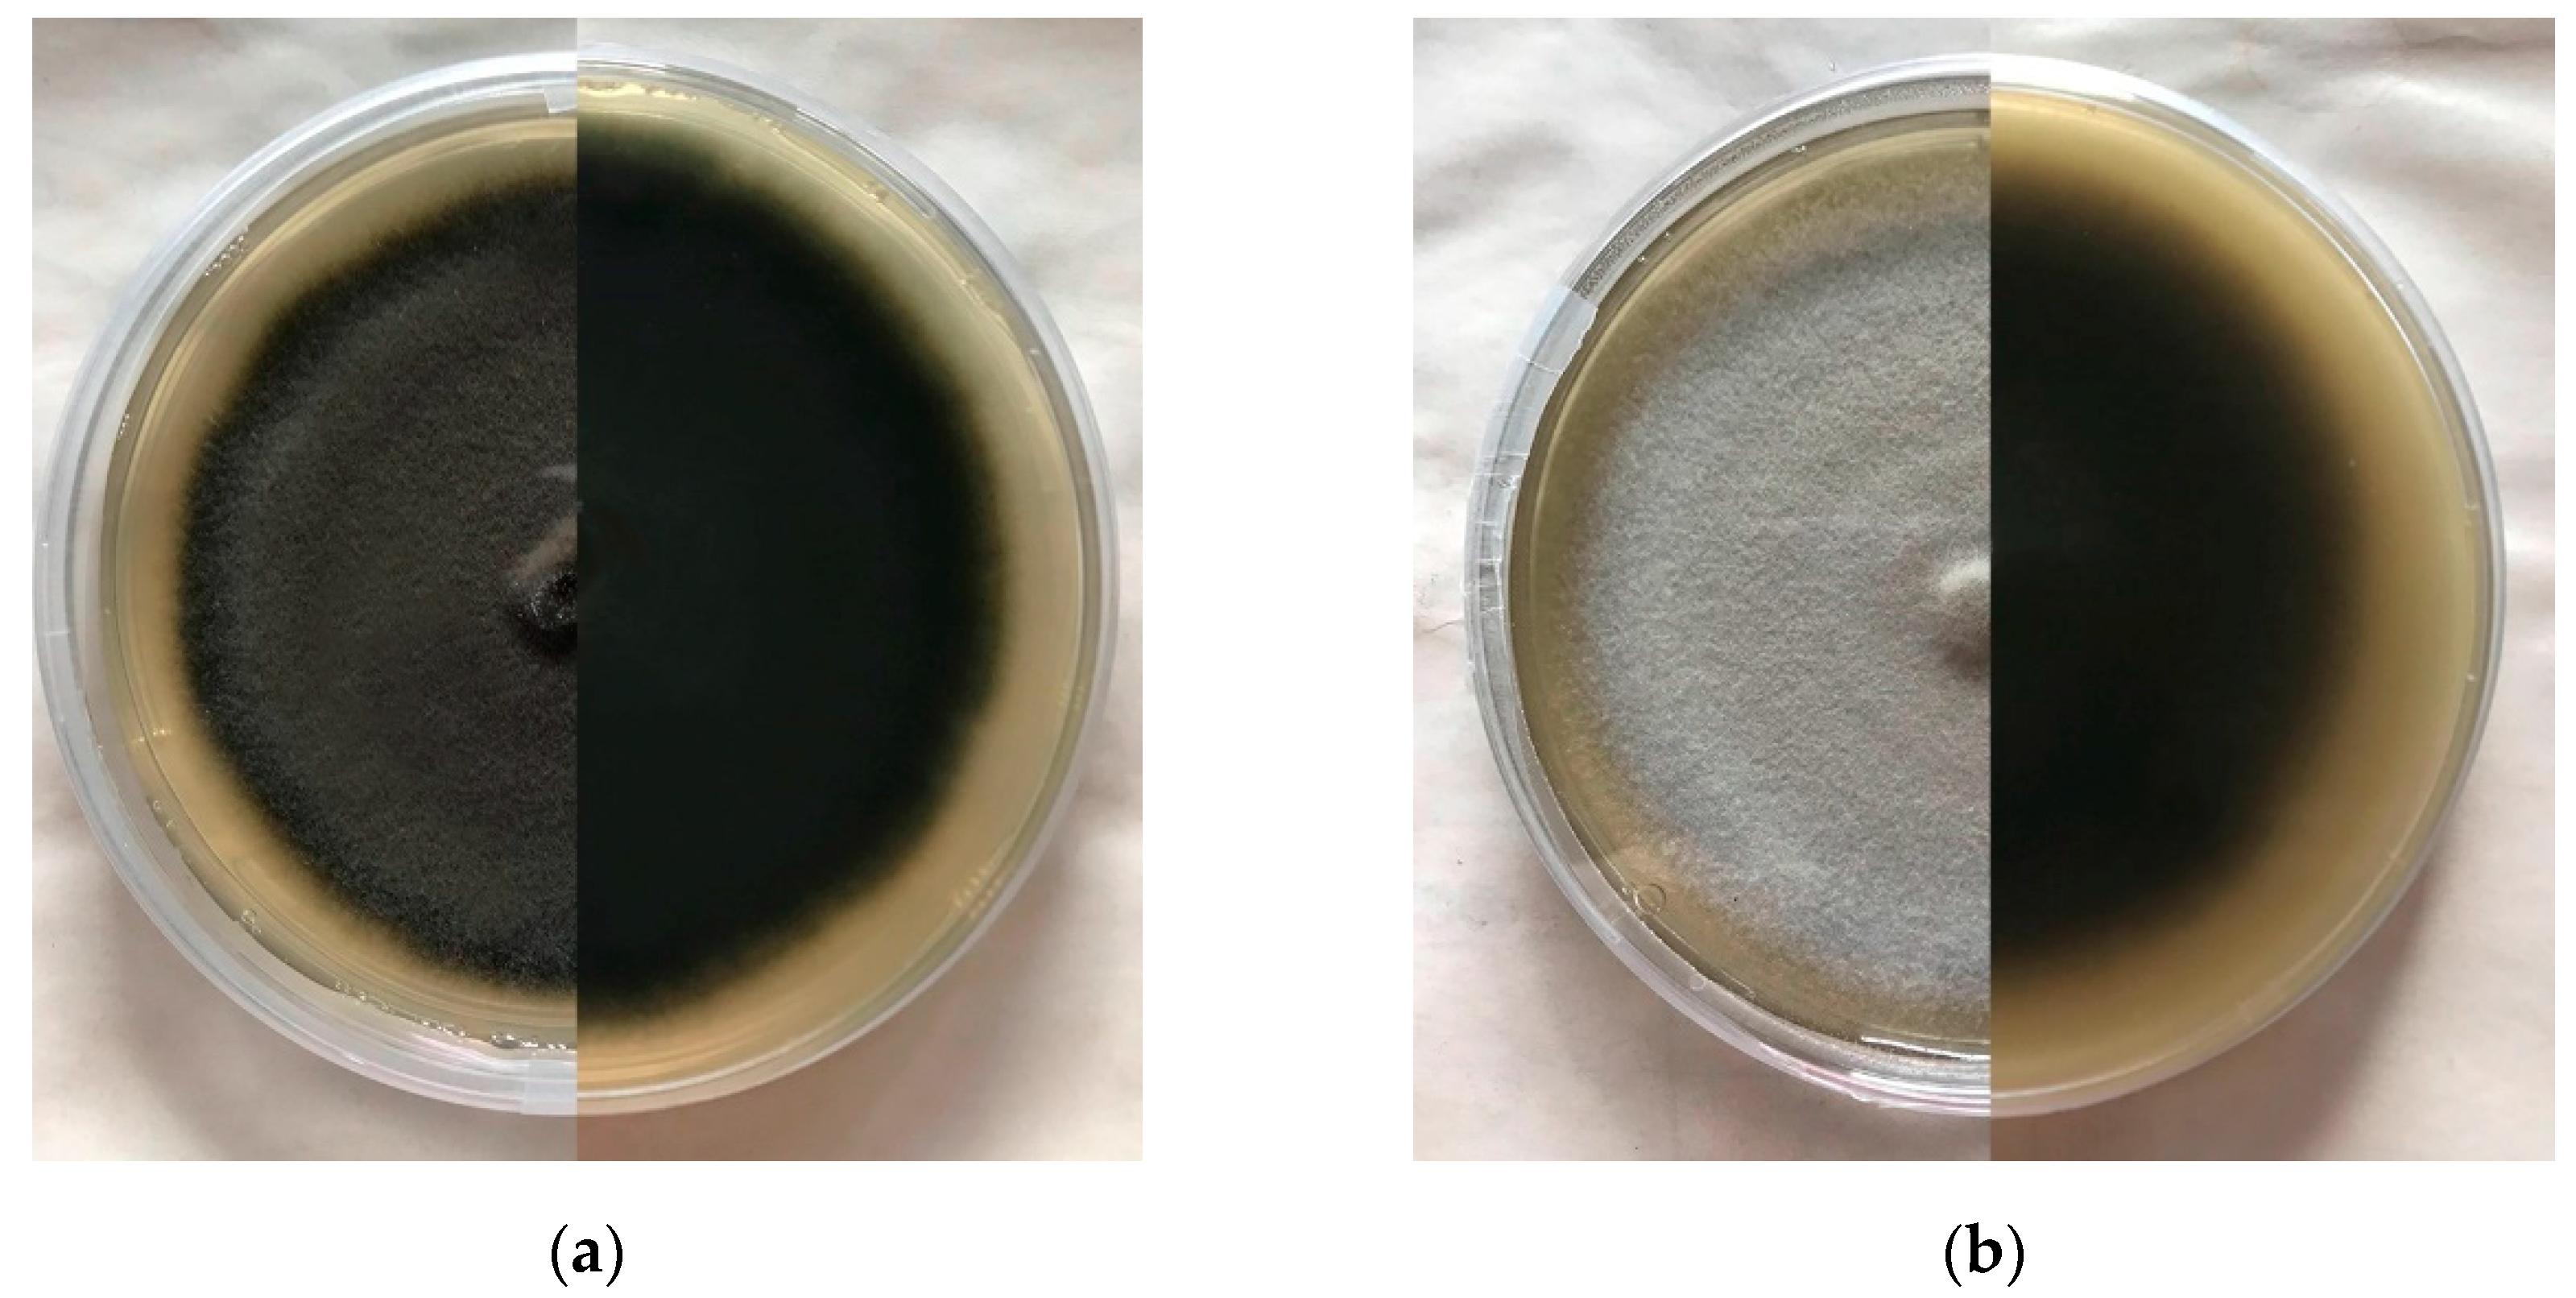

The Potential of Esteya spp. for the Biocontrol of the Pinewood Nematode, Bursaphelenchus xylophilus
Abstract
1. Introduction
2. Taxonomy, Morphology and Distribution of Esteya Species
2.1. Taxonomy and Phylogeny
2.2. Morphology
2.3. Distribution and Host Range
3. Parasitism of Esteya spp. on the PWN
4. Application of Esteya spp. for a Sustainable PWD Management
4.1. Culturing
4.2. Mass Production and Maintenance
4.3. Implications for Field Use and Biocontrol Strategies
5. Future Perspectives
Author Contributions
Funding
Acknowledgments
Conflicts of Interest
References
- EPPO Global Database. Available online: https://gd.eppo.int/taxon/BURSXY/categorization (accessed on 18 November 2021).
- Evans, H.; McNamara, D.; Braasch, H.; Chadouef, J.; Magnusson, C. Pest risk analysis (PRA) for the territories of the European Union (as PRA area) on Bursaphelenchus xylophilus and its vectors in the genus Monochamus. EPPO Bull. 1996, 26, 199–249. [Google Scholar] [CrossRef]
- Futai, K. Pine wood nematode, Bursaphelenchus xylophilus. Annu. Rev. Phytopathol. 2013, 51, 61–83. [Google Scholar] [CrossRef]
- Jones, J.T.; Haegeman, A.; Danchin, E.G.J.; Gaur, H.S.; Helder, J.; Jones, M.G.K.; Kikuchi, T.; Manzanilla-López, R.; Palomares-Rius, J.E.; Wesemael, W.M.L.; et al. Top 10 plant-parasitic nematodes in molecular plant pathology. Mol. Plant Pathol. 2013, 14, 946–961. [Google Scholar] [CrossRef] [PubMed]
- Mamiya, Y. Pathology of the pine wilt disease caused by Bursaphelenchus xylophilus. Annu. Rev. Phytopathol. 1983, 21, 201–220. [Google Scholar] [CrossRef]
- Zhao, B.G.; Futai, K.; Sutherland, J.R.; Takeuchi, Y. Pine Wilt Disease; Springer: Tokyo, Japan, 2008. [Google Scholar]
- Naves, P.; Bonifácio, L.; Sousa, E. Nematode-Vector. In Pine Wilt Disease in Europe: Biological Interactions and Integrated Management, 1st ed.; Sousa, E., Vale, F., Abrantes, I., Eds.; FNAPF—Federação Nacional das Associações de Proprietários Florestais: Lisbon, Portugal, 2015; pp. 81–122. [Google Scholar]
- Schenk, M.; Loomans, A.; den Nijs, L.; Hoppe, B.; Kinkar, M.; Vos, S. Pest Survey Card on Bursaphelenchus xylophilus; EFSA Supporting Publication; EFSA: Parma, Italy, 2020; EN-1782; pp. 1–32. [Google Scholar] [CrossRef]
- Jones, J.T.; Moens, M.; Mota, M.; Li, H.; Kikuchi, T. Bursaphelenchus xylophilus: Opportunities in comparative genomics and molecular host-parasite interactions. Mol. Plant Pathol. 2008, 9, 357–368. [Google Scholar] [CrossRef] [PubMed]
- Tokushige, Y.; Kiyohara, T. Bursaphelenchus sp. in the wood of dead pine trees. J. Jap. For. Soc. 1969, 51, 193–195. [Google Scholar] [CrossRef]
- Kiyohara, T.; Tokushige, Y. Inoculation experiments of a nematode, Bursaphelenchus sp., onto pine trees. J. Jap. For. Soc. 1971, 53, 210–218. [Google Scholar] [CrossRef]
- Sousa, E.; Vale, F.; Abrantes, I. Pine Wilt Disease in Europe: Biological Interactions and Integrated Management, 1st ed.; FNAPF—Federação Nacional das Associações de Proprietários Florestais: Lisbon, Portugal, 2015; pp. 35–84. [Google Scholar]
- Robinet, C.; Castagnone-Sereno, P.; Mota, M.; Roux, G.; Sarniguet, C.; Tassus, X.; Jactel, H. Effectiveness of clear-cuttings in non-fragmented pine forests in relation to EU regulations for the eradication of the pine wood nematode. J. Appl. Ecol. 2019, 57, 460–466. [Google Scholar] [CrossRef]
- Carnegie, A.J.; Venn, T.; Lawson, S.; Nagel, M.; Wardlaw, T.; Cameron, N.; Last, I. An analysis of pest risk and potential economic impact of pine wilt disease to Pinus plantations in Australia. Aust. For. 2018, 81, 24–36. [Google Scholar] [CrossRef]
- Soliman, T.; Mourits, M.C.; van der Werf, W.; Hengeveld, G.M.; Robinet, C.; Lansink, A.G. Framework for modelling economic impacts of invasive species, applied to pine wood nematode in Europe. PLoS ONE 2012, 7, e45505. [Google Scholar] [CrossRef] [PubMed]
- Webster, J.; Mota, M. Global issues, trade and economic impact. In Pine Wilt Disease: A Worldwide Threat to Forest Ecosystems, 1st ed.; Mota, M., Vieira, P., Eds.; Springer: Dordrecht, The Netherlands, 2008; pp. 1–4. [Google Scholar]
- Kiyohara, T.; Bolla, R.I. Pathogenic variability among populations of the pinewood nematode, Bursaphelenchus xylophilus. For. Sci. 1990, 36, 1061–1076. [Google Scholar] [CrossRef]
- Suzuki, K. Pine wilt disease—A threat to pine forest in Europe. Dendrobiology 2002, 48, 71–74. [Google Scholar]
- An, H.; Lee, S.; Cho, S.J. The effects of climate change on pine wilt disease in South Korea: Challenges and prospects. Forests 2019, 10, 486. [Google Scholar] [CrossRef]
- Hirata, A.; Nakamura, K.; Nakao, K.; Kominami, Y.; Tanaka, N.; Ohashi, H.; Takano, K.T.; Takeuchi, W.; Matsui, T. Potential distribution of pine wilt disease under future climate change scenarios. PLoS ONE 2017, 12, e0182837. [Google Scholar] [CrossRef] [PubMed]
- Tang, X.; Yuan, Y.; Li, X.; Zhang, J. Maximum entropy modeling to predict the impact of climate change on pine wilt disease in China. Front. Plant Sci. 2021, 12, 652500. [Google Scholar] [CrossRef] [PubMed]
- Wang, Z.; Zhang, Y.; Wang, C.; Wang, Y.; Sung, C. Esteya vermicola controls the pinewood nematode, Bursaphelenchus xylophilus, in pine seedlings. J. Nematol. 2017, 49, 86–91. [Google Scholar] [CrossRef] [PubMed]
- Wang, Z.; Wang, C.Y.; Yang, Z.; Fang, Z.; Moon, Y.; Sun, B.; Lee, M.R.; Sung, C. Viability and pathogenicity of Esteya vermicola in pine trees. Biocontrol Sci. Technol. 2011, 21, 387–393. [Google Scholar] [CrossRef]
- Vicente, C.S.L.; Soares, M.; Faria, J.M.S.; Ramos, A.P.; Inácio, M.L. Insights into the role of fungi in pine wilt disease. J. Fungi 2021, 7, 780. [Google Scholar] [CrossRef] [PubMed]
- Liou, J.Y.; Shih, J.Y.; Tzean, S.S. Esteya, a new nematophagous genus from Taiwan, attacking the pinewood nematode (Bursaphelenchus xylophilus). Mycol. Res. 1999, 103, 242–248. [Google Scholar] [CrossRef]
- Li, Y.; Yu, H.; Araújo, J.; Zhang, X.; Ji, Y.; Hulcr, J. Esteya floridanum sp. nov.: An Ophiostomatalean nematophagous fungus and its potential to control the pine wood nematode. Phytopathology 2021, 111, 304–311. [Google Scholar] [CrossRef]
- Chu, W.H.; Dou, Q.; Chu, H.; Wang, H.H.; Sung, C.; Wang, C. Research advance on Esteya vermicola, a high potential biocontrol agent of pine wilt disease. Mycol. Prog. 2015, 14, 115. [Google Scholar] [CrossRef]
- Wang, C.Y.; Fang, Z.M.; Wang, Z.; Zhang, D.L.; Gu, L.J.; Lee, M.R.; Liu, L.; Sung, C.K. Biological control of the pinewood nematode Bursaphelenchus xylophilus by application of the endoparasitic fungus Esteya vermicola. BioControl 2010, 56, 91–100. [Google Scholar] [CrossRef]
- Wang, C.Y.; Yin, C.; Fang, Z.M.; Wang, Z.; Wang, Y.B.; Xue, J.J.; Gu, L.J.; Sung, C.K. Using the nematophagous fungus Esteya vermicola to control the disastrous pine wilt disease. Biocontrol. Sci. Technol. 2018, 28, 268–277. [Google Scholar] [CrossRef]
- Fang, Z.M.; Wang, C.Y.; Wang, Z.; Gu, L.J.; Lee, Q.H.; Lee, M.R.; Sung, C.K. A Biocontrol Agent of Pinewood Nematode and Application Method. South. Korea Patent 10-1033270, 21 June 2010. [Google Scholar]
- Tzean, S.S.; Liou, J.Y.; Shih, J.Y. Nematophagous fungus Esteya vermicola. U.S. Patent 006168947B1, 2 January 2001. [Google Scholar]
- Wang, R.; Dong, L.; Chen, Y.; Qu, L.; Li, E.; Wang, Q.; Zhang, Y. The complete mitochondrial genome of nematophagous fungus Esteya vermicola. Mitochondrial DNA B: Resour. 2017, 2, 196–197. [Google Scholar] [CrossRef] [PubMed][Green Version]
- Kim, J.J.; Lim, Y.W.; Breull, C.; Wingfield, M.J.; Zhou, X.D.; Kim, G.H. A new Leptographium species associated with Tomicus piniperda infesting pine logs in Korea. Mycol. Res. 2005, 109, 275–284. [Google Scholar] [CrossRef]
- Westerdijk Fungal Biodiversity Institute. Available online: https://wi.knaw.nl/page/fungal_display/28844 (accessed on 14 December 2021).
- Wang, C.Y.; Fang, Z.M.; Wang, Z.; Gu, L.J.; Sun, B.S.; Zhang, D.L.; Sung, C.K. High infection activities of two Esteya vermicola isolates against pinewood nematode. Afr. J. Microbiol. Res. 2009, 3, 581–584. [Google Scholar] [CrossRef]
- Wang, C.Y.; Fang, Z.M.; Sun, B.S.; Gu, L.J.; Zhang, K.Q.; Sung, C.K. High infectivity of an endoparasitic fungus strain, Esteya vermicola, against nematodes. J. Microbiol. 2008, 46, 380–389. [Google Scholar] [CrossRef] [PubMed]
- Wang, X.; Wang, T.T.; Wang, J.C.; Guan, T.L.; Li, H.M. Morphological, molecular and biological characterization of Esteya vermicola, a nematophagous fungus isolated from intercepted wood packing materials exported from Brazil. Mycoscience 2014, 55, 367–377. [Google Scholar] [CrossRef]
- Yin, C.; Wang, Y.; Zhang, Y.; Wang, H.; Tao, R.; Li, Y.; Sung, C.K. A pine wood sample preparation method for high target and quality DNA extraction for detection of Esteya vermicola by PCR from living pine. J. Basic Microbiol. 2019, 59, 437–441. [Google Scholar] [CrossRef]
- Glass, N.L.; Donaldson, G.C. Development of primer sets designed for use with the PCR to amplify conserved genes from filamentous ascomycetes. Appl. Environ. Microbiol. 1995, 61, 1323–1330. [Google Scholar] [CrossRef]
- O’Donnell, K.; Cigelnik, E. Two divergent intragenomic rDNA ITS2 types within a monophyletic lineage of the fungus Fusarium are nonorthologous. Mol. Phylogenet. Evol. 1997, 7, 103–116. [Google Scholar] [CrossRef] [PubMed]
- Rehner, S.A.; Buckley, E. A Beauveria phylogeny inferred from nuclear ITS and EF1-α sequences: Evidence for cryptic diversification and links to Cordyceps teleomorphs. Mycologia 2005, 97, 84–98. [Google Scholar] [CrossRef]
- Hopple, J.S., Jr. Phylogenetic Investigations in the Genus Coprinus Based on Morphological and Molecular Characters. Ph.D. Thesis, Duke University, Durham, NC, USA, 1994. [Google Scholar]
- Vilgalys, R.; Hester, M. Rapid genetic identification and mapping of enzymatically amplified ribosomal DNA from several Cryptococcus species. J. Bacteriol. 1990, 172, 4238–4246. [Google Scholar] [CrossRef] [PubMed]
- Gardes, M.; Bruns, T.D. ITS Primers with enhanced specificity for Basidiomycetes—Application to the identification of mycorrhizae and rusts. Mol. Ecol. 1993, 2, 113–118. [Google Scholar] [CrossRef]
- White, T.J.; Bruns, T.D.; Lee, S.B.; Taylor, J.W. Amplification and direct sequencing of fungal ribosomal RNA genes for phylogenetics. In PCR Protocols: A Guide to Methods and Applications; Innis, M.A., Gelfand, D.H., Sninsky, J.J., White, T.J., Eds.; Academic Press: Cambridge, MA, USA, 1990; Volume 18, pp. 315–322. [Google Scholar]
- Jankowiak, R.; Strzałka, B.; Bilański, P.; Kacprzyk, M.; Wieczorek, P.; Linnakoski, R. Ophiostomatoid fungi associated with hardwood-infesting bark and ambrosia beetles in Poland: Taxonomic diversity and vector specificity. Fungal Ecol. 2019, 39, 152–167. [Google Scholar] [CrossRef]
- National Center for Biotechnology Information Taxonomy Database. Available online: https://www.ncbi.nlm.nih.gov/Taxonomy/Browser/wwwtax.cgi?id=522481 (accessed on 14 December 2021).
- Kubátová, A.; Novotný, D.; Prášil, K.; Mráček, Z. The nematophagous hyphomycete Esteya vermicola found in the Czech Republic. Czech Mycol. 2000, 52, 227–235. [Google Scholar] [CrossRef]
- Wang, H.M.; Wang, Z.; Liu, F.; Wu, C.X.; Zhang, S.F.; Kong, X.B.; Decock, C.; Lu, Q.; Zhang, Z. Differential patterns of ophiostomatoid fungal communities associated with three sympatric Tomicus species infesting pines in south-western China, with a description of four new species. MycoKeys 2019, 50, 93–133. [Google Scholar] [CrossRef]
- Wang, R.; Dong, L.; He, R.; Wang, Q.; Chen, Y.; Qu, L.; Zhang, Y.A. Comparative genomic analyses reveal the features for adaptation to nematodes in fungi. DNA Res. 2018, 25, 245–256. [Google Scholar] [CrossRef] [PubMed]
- Lehenberger, M.; Benkert, M.; Biedermann, P.H.W. Ethanol-enriched substrate facilitates ambrosia beetle fungi, but inhibits their pathogens and fungal symbionts of bark beetles. Front. Microbiol. 2021, 11, 590111. [Google Scholar] [CrossRef]
- De Beer, Z.W.; Duong, T.A.; Wingfield, M.J. The divorce of Sporothrix and Ophiostoma: Solution to a problematic relationship. Stud. Mycol. 2016, 83, 165–191. [Google Scholar] [CrossRef] [PubMed]
- Zubaer, A.; Wai, A.; Patel, N.; Perillo, J.; Hausner, G. The mitogenomes of Ophiostoma minus and Ophiostoma piliferum and comparisons with other members of the Ophiostomatales. Front. Microbiol. 2021, 12, 618649. [Google Scholar] [CrossRef] [PubMed]
- De Beer, Z.W.; Wingfield, M.J. Emerging lineages in the Ophiostomatales. In Ophiostomatoid fungi: Expanding Frontiers; Seifert, K.A., De Beer, Z.W., Wingfield, M.J., Eds.; Series 12; CBS-KNAW Biodiversity: Utrecht, The Netherlands, 2013; pp. 21–46. [Google Scholar]
- Wang, X.; Guan, T.; Zhang, L.; Li, H. Cloning of a serine protease gene from the nematophagous fungus Esteya vermicola and expressed activity of the recombinant enzyme against Bursaphelenchus xylophilus. Nematology 2015, 17, 1071–1080. [Google Scholar] [CrossRef]
- Wang, R.; Dong, L.; Chen, Y.; Qu, L.; Wang, Q.; Zhang, Y. Esteya vermicola, a nematophagous fungus attacking the pine wood nematode, harbors a bacterial endosymbiont affiliated with Gammaproteobacteria. Microbes Environ. 2017, 32, 201–209. [Google Scholar] [CrossRef]
- Li, Y.; Huang, Y.T.; Kasson, M.T.; Macias, A.M.; Skelton, J.; Carlson, P.S.; Yin, M.; Hulcr, J. Specific and promiscuous ophiostomatalean fungi associated with Platypodinae ambrosia beetles in the southeastern United States. Fungal Ecol. 2018, 35, 42–50. [Google Scholar] [CrossRef]
- Cruz, L.F.; Menocal, O.; Kendra, P.E.; Carrillo, D. Phoretic and internal transport of Raffaelea lauricola by different species of ambrosia beetle associated with avocado trees. Symbiosis 2021, 84, 151–161. [Google Scholar] [CrossRef]
- Restrepo, M.A. Escarabajos Ambrosiales y Sus Hongos Simbiontes Asociados al Cultivo de Aguacate “Hass” en Michoacán. Master’s Thesis, Universidad Michoacana de San Nicolás de Hidalgo, Morelia, Mexico, 2019. [Google Scholar]
- Jordal, B.H. Molecular phylogeny and biogeography of the weevil subfamily Platypodinae reveals evolutionarily conserved range patterns. Mol. Phylogenet. Evol. 2015, 92, 294–307. [Google Scholar] [CrossRef] [PubMed]
- Six, D.L. Ecological and evolutionary determinants of bark beetle—Fungus symbioses. Insects 2012, 3, 339–366. [Google Scholar] [CrossRef]
- Inácio, M.L.; Marcelino, J.; Lima, A.; Sousa, E.; Nóbrega, F. Raffaelea quercina sp. nov. associated with cork oak (Quercus suber L.) decline in Portugal. Forests 2021, 12, 513. [Google Scholar] [CrossRef]
- Zhang, K.Q.; Hyde, K.D. Nematode-Trapping Fungi; Springer: Dordrecht, The Netherlands, 2014. [Google Scholar]
- Lin, F.; Ye, J.L.; Wang, H.G.; Zhang, A.J.; Zhao, B.G. Host deception: Predaceous fungus, Esteya vermicola, entices pine wood nematode by mimicking the scent of pine tree for nutrient. PLoS ONE 2013, 8, e71676. [Google Scholar] [CrossRef]
- Wang, C.Y.; Wang, Z.; Lee, M.L.; Li, Z.; Zhang, D.L.; Liu, L.; Fang, Z.M.; Sung, C.K. Attraction of pinewood nematode, Bursaphelenchus xylophilus, to the endoparasitic fungus Esteya vermicola. Afr. J. Microbiol. Res. 2009, 3, 782–786. [Google Scholar] [CrossRef]
- Wang, C.Y.; Wang, Z.; Fang, Z.M.; Zhang, D.L.; Gu, L.J.; Liu, L.; Sung, C.K. Attraction of pinewood nematode to endoparasitic nematophagous fungus Esteya vermicola. Curr. Microbiol. 2010, 60, 387–392. [Google Scholar] [CrossRef]
- Wang, H.H.; Wang, Y.B.; Yin, C.; Gao, J.; Tao, R.; Sun, Y.L.; Wang, C.Y.; Wang, Z.; Li, Y.X.; Sung, C.K. In vivo infection of Bursaphelenchus xylophilus by the fungus Esteya vermicola. Pest Manag. Sci. 2020, 76, 2854–2864. [Google Scholar] [CrossRef]
- Yin, C.; Wang, Y.; Zhang, Y.; Wang, H.; Duan, B.; Tao, R.; Gao, J.; Sung, C.K. Hypothesized mechanism of biocontrol against pine wilt disease by the nematophagous fungus Esteya vermicola. Eur. J. Plant Pathol. 2020, 156, 811–818. [Google Scholar] [CrossRef]
- Wang, H.; Chu, H.; Xie, Q.; Dou, Q.; Feng, H.; Yang, C.; Wang, C. Variation in sporulation of four Esteya vermicola isolates and their infectivity against pinewood nematode. Sci. Silvae Sin. 2016, 52, 139–146. [Google Scholar]
- Wang, H.H.; Yin, C.; Tao, R.; Gao, J.; Sun, Y.L.; Cho, J.H.; Wang, Z.; Wang, Y.B.; Wang, C.Y.; Sung, C.K. Migration of pinewood nematode promotes the colonization of Esteya vermicola in pine tree. For. Pathol. 2021, 51, e12668. [Google Scholar] [CrossRef]
- Rabiey, M.; Hailey, L.E.; Roy, S.R.; Grenz, K.; Al-Zadjali, M.A.; Barrett, G.A.; Jackson, R.W. Endophytes vs. tree pathogens and pests: Can they be used as biological control agents to improve tree health? Eur. J. Plant Pathol. 2019, 155, 711–729. [Google Scholar] [CrossRef]
- Berg, R.H.; Fester, T.; Taylor, C.G. Cell Biology of Plant Nematode Parasitism. In Plant Cell Monographs; Berg, R.H., Taylor, C.G., Eds.; Springer: Berlin/Heidelberg, Germany, 2009; Volume 15, pp. 115–152. [Google Scholar]
- Kikuchi, T.; Shibuya, H.; Jones, J.T. Molecular and biochemical characterization of an endo-beta-1,3-glucanase from the pinewood nematode Bursaphelenchus xylophilus acquired by horizontal gene transfer from bacteria. Biochem. J. 2005, 389, 117–125. [Google Scholar] [CrossRef]
- Wang, Y.B.; Yang, Z.H.; Yu, J.J.; Zhang, Y.A.; Xue, J.J.; Li, Z.; Li, J.J.; Wang, C.Y.; Wang, Z.; Hou, J.G.; et al. Comparison between conidia and blastospores of Esteya vermicola, an endoparasitic fungus of the pinewood nematode, Bursaphelenchus xylophilus. World J. Microbiol. Biotechnol. 2013, 29, 2429–2436. [Google Scholar] [CrossRef]
- Wang, Z.; Wang, C.Y.; Gu, L.J.; Wang, Y.B.; Zhang, Y.A.; Sung, C.K. Growth of Esteya vermicola in media amended with nitrogen sources yields conidia with increased predacity and resistance to environmental stress. Can. J. Microbiol. 2011, 57, 838–843. [Google Scholar] [CrossRef]
- Wang, Z.; Wang, C.; Liu, M.; Zhang, Y.; Xue, J.; Wang, Y.; Li, Z.; Hou, Z.; Li, J.; Sung, C. Effects of mineral salts on the growth, sporulation and virulence of Esteya vermicola, an endoparasitic fungus of the pinewood nematode, Bursaphelenchus xylophilus. Biocontrol Sci. Technol. 2011, 21, 1485–1493. [Google Scholar] [CrossRef]
- Ward, E.; Kerry, B.R.; Manzanilla-López, R.H.; Mutua, G.; Devonshire, J.; Kimenju, J.; Hirsch, P.R. The Pochonia chlamydosporia serine protease gene vcp1 is subject to regulation by carbon, nitrogen and pH: Implications for nematode biocontrol. PLoS ONE 2012, 7, e35657. [Google Scholar] [CrossRef]
- Xue, J.; Hou, J.; Zhang, Y.; Wang, Y.; Lee, M.; Yu, J.; Sung, C. Optimization of promoting conidial production of a pinewood nematode biocontrol fungus, Esteya vermicola using response surface methodology. Curr. Microbiol. 2014, 69, 745–750. [Google Scholar] [CrossRef]
- Zhu, Y.; Mao, Y.; Ma, T.; Wen, X. Effect of culture conditions on conidia production and enhancement of environmental stress resistance of Esteya vermicola in solid-state fermentation. J. Appl. Microbiol. 2021, 131, 404–412. [Google Scholar] [CrossRef] [PubMed]
- Wang, Y.B.; Wang, C.Y.; Wang, Z.; Xue, J.J.; Li, Z.; Li, J.J.; Gu, L.J.; Hou, J.G.; Lee, M.R.; Ma, R.S.; et al. Laboratory studies on the development of a conidial formulation of Esteya vermicola. Biocontrol Sci. Technol. 2012, 22, 1362–1372. [Google Scholar] [CrossRef]
- Xue, J.; Hou, J.; Zhang, Y.; Wang, Y.; Wang, C.; Wang, Z.; Wang, Y.; Sung, C. A method for the enhancement of environmental stress resistance of endoparasitic fungus Esteya vermicola. J. Phytopathol. 2013, 161, 353–358. [Google Scholar] [CrossRef]
- Feng, M.G.; Poprawski, T.J.; Khachatourians, G.G. Production, formulation and application of the entomopathogenic fungus Beauveria bassiana for insect control: Current status. Biocontrol Sci. Technol. 1994, 4, 3–34. [Google Scholar] [CrossRef]
- Jenkins, N.E.; Prior, C. Growth and formation of true conidia by Metrahizium flavoviride in a simple liquid medium. Mycol. Res. 1993, 97, 1489–1494. [Google Scholar] [CrossRef]
- Wraight, S.P.; Jackson, M.A.; deKock, S.L. Production, stabilization and formulation of fungal biocontrol agents. In Fungal Biocontrol agents—progress, problems and potential; Butt, T., Jackson, C., Magan, N., Eds.; CABI International: Wallingford, UK, 2001; pp. 253–287. [Google Scholar]
- Roberts, D.W.; St. Leger, R.J. Metarhizium spp., cosmopolitan insect-pathogenic fungi: Mycological aspects. Adv. Appl. Microbiol. 2004, 54, 1–70. [Google Scholar] [CrossRef] [PubMed]

| Species | Strain | Origin | Year | Substrate | Reference |
|---|---|---|---|---|---|
| E. vermicola | CBS 156.82 | Japan | 1982 | Dried Pinus | [34,35] |
| ATCC 74485T | Taiwan | 1995 | Infected PWNs from Pinus thunbergii | [25] | |
| CBS 100821 | Italy | 1998 | Twig of Olea europaea | [35] | |
| CBS 115803 | Czech Republic | 1999 | Scolytus intricatus from oak tree | [48] | |
| CNU 120806 | South Korea | 2006 | Infected nematodes in forest soil | [35] | |
| NKF 13222 | Brazil | 2014 | Infected Bursaphelenchus rainulfi from wood packing materials | [37] | |
| CXY 1893 | China | 2016 | Galleries of Tomicus yunnanensis | [49] | |
| FXY 121 | China | 2021 | Pinus yunnanensis | [unpublished] | |
| E. floridanum | 14639 | United States | 2017 | Head of Myoplatypus flavicornis | [26] |
Publisher’s Note: MDPI stays neutral with regard to jurisdictional claims in published maps and institutional affiliations. |
© 2022 by the authors. Licensee MDPI, Basel, Switzerland. This article is an open access article distributed under the terms and conditions of the Creative Commons Attribution (CC BY) license (https://creativecommons.org/licenses/by/4.0/).
Share and Cite
Pires, D.; Vicente, C.S.L.; Inácio, M.L.; Mota, M. The Potential of Esteya spp. for the Biocontrol of the Pinewood Nematode, Bursaphelenchus xylophilus. Microorganisms 2022, 10, 168. https://doi.org/10.3390/microorganisms10010168
Pires D, Vicente CSL, Inácio ML, Mota M. The Potential of Esteya spp. for the Biocontrol of the Pinewood Nematode, Bursaphelenchus xylophilus. Microorganisms. 2022; 10(1):168. https://doi.org/10.3390/microorganisms10010168
Chicago/Turabian StylePires, David, Cláudia S. L. Vicente, Maria L. Inácio, and Manuel Mota. 2022. "The Potential of Esteya spp. for the Biocontrol of the Pinewood Nematode, Bursaphelenchus xylophilus" Microorganisms 10, no. 1: 168. https://doi.org/10.3390/microorganisms10010168
APA StylePires, D., Vicente, C. S. L., Inácio, M. L., & Mota, M. (2022). The Potential of Esteya spp. for the Biocontrol of the Pinewood Nematode, Bursaphelenchus xylophilus. Microorganisms, 10(1), 168. https://doi.org/10.3390/microorganisms10010168
